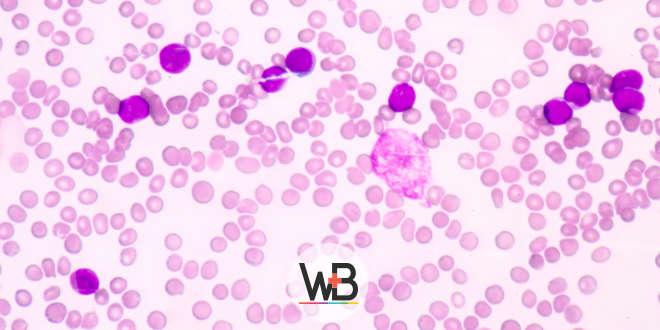
whitebook

Mais notícias

Cardiologia
ESC 2019: vacina da gripe reduz mortalidade em hipertensos
01 setembro 2019|

Cardiologia
ESC 2019: Sangramento com DAPT pode ser por neoplasia oculta
31 agosto 2019|

Saúde
Cédulas de identidade médica digital serão adotadas em breve
30 agosto 2019|

Clínica Médica
Menos sedativos e mais horas de sono em pacientes internados
29 agosto 2019|

Clínica Médica
Caso Clínico: idoso com dor intensa em abdome e dorso há 4 meses
29 agosto 2019|

Saúde
As oito maiores necessidades dos pacientes crônicos
29 agosto 2019|

Saúde
Metade dos pacientes não relata aos médicos detalhes que ameaçam as suas vidas
27 agosto 2019|

Cardiologia
Cirurgia vs endovascular para isquemia crítica de membros inferiores
14 agosto 2019|
Anúncio

Hematologia
Reposição de ferro: indicações na anemia ferropriva e em outras condições
6 novembro 2024|4 min.

Terapia Intensiva
Dose de noradrenalina: você está interpretando a dose corretamente?
2 fevereiro 2024|7 min.

Endocrinologia
Agonistas de GLP-1 na redução de peso e na saúde cardiovascular em obesos
8 setembro 2025|13 min.

Medicina de Família
Guia rápido do atendimento à mordedura no plantão
13 maio 2024|7 min.
Anúncio


![Check-up Semanal #Clínica Médica: omeprazol, TCE, IC, astenia e mais! [podcast]](/_next/image?url=https%3A%2F%2Fuploads.production.portal.marketing.afya.systems%2Fwp-content%2Fuploads%2F2026%2F03%2F30152440%2Fportal_checkup_semanal_clinica_medica.jpg&w=3840&q=75)
![Check-up Semanal #Clínica Médica: aspirina e anticoagulação, DM2 e mais! [podcast]](/_next/image?url=https%3A%2F%2Fuploads.production.portal.marketing.afya.systems%2Fwp-content%2Fuploads%2F2026%2F01%2F26123158%2Fportal_checkup_semanal_ClinicaMedica_05_01.jpg&w=1920&q=75)
![Check-up Semanal #ClínicaMédica: DM2, fluidoterapia e mais [podcast]](/_next/image?url=%2Fimages%2Fplaceholder%2Fplaceholder.png&w=1920&q=75)


![Tomada De Decisão — Caso Clínico: Infecção urinária [vídeo]](/_next/image?url=https%3A%2F%2Fuploads.production.portal.marketing.afya.systems%2Fwp-content%2Fuploads%2F2025%2F11%2F10102121%2Fthumb_yt_Tomada_de_Decisao_Day.png&w=3840&q=75)
![Tomada De Decisão — Caso Clínico: Pneumonia Comunitária [vídeo]](/_next/image?url=https%3A%2F%2Fuploads.production.portal.marketing.afya.systems%2Fwp-content%2Fuploads%2F2025%2F10%2F29103657%2Fthumb_yt_Tomada_de_Decisao_Yuri.png&w=1920&q=75)
![Tomada De Decisão — Caso Clínico: Confusão Mental [vídeo]](/_next/image?url=https%3A%2F%2Fuploads.production.portal.marketing.afya.systems%2Fwp-content%2Fuploads%2F2025%2F10%2F09135344%2Fthumb_portal_Tomada_de_Decisao_Larissa.jpg&w=1920&q=75)